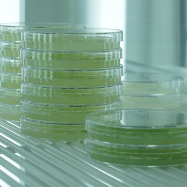

組織改編に伴い修正中(しばらくお待ちください)
モデル植物研究支援施設(諸岡)
快適な環境づくり・・・人のためではなく。
生命科学の研究は興味深い現象を持つ生き物を育てることから始まるといっても過言ではありません。
そのために、対象となる生き物がすくすく育つような最適な生育環境を与えることが重要となります。
モデル生物研究センターモデル植物研究支援室の技術職員・支援員は研究者が育てたい植物に合わせた環境づくりを通じて研究活動に貢献しています。
また、LEDを使った照射装置や光強度などを測る装置も提供しています。
植物栽培室

植物を大量に育てるための部屋です。
部屋の環境をその植物に適した温度、光条件に厳密に制御しています
正常に動いているかのチェックは欠かせません。所内に点在する栽培室全室を毎日点検しています。また、おんどとり(T&D社製)を用いて各部屋の温度をモニターするシステムも構築し、遠隔監視を可能にしています。
インキュベーター

大型の冷蔵庫のような装置で温度や光を厳密に制御し、植物の生育に最適な環境を提供します。こちらも毎日数十台の動作を確認しています。
LED培養棚

いろんな色のLEDをサンプルに当てて応答を見ています。
植物に限らず、ミジンコを用いた実験に使用されたこともあります。
モデル動物研究支援施設(大澤・野口)
動物たちがきれいに、快適に過ごせる場所。
植物と同様に動物を用いた研究をするためには対象となる動物(マウス、魚類など)を育てる環境が必要となります。
モデル生物研究センターモデル動物研究支援室の技術職員・支援員は動物飼育施設の維持管理を通じて研究活動に貢献しています。
最近ではゲノム編集技術を導入したマウスの作製にも挑戦しています。
トランスオミクス解析室(森・牧野・山口)
遺伝子・タンパク質解析の共同利用拠点
生物機能情報分析室は遺伝子・タンパク質解析の共同利用拠点として、機能ゲノミクス分野で所内外の研究者との共同利用研究を進めています。室の技術職員・支援員は、共通機器の適切な管理・運用と技術サポートを行っています。またセミナー等を通して、情報共有と人的ネットワークの構築を促進しています。
共同利用研究

生物機能情報分析室が運用する次世代 DNA シーケンサーや質量分析装置を活用する共同研究を推進しています。技術職員・支援員は研究の打ち合わせから実験・データ解析まで幅広く研究者のサポートを行っています。
共通機器

40 種類 70 台にのぼる多数の共通機器を管理・運営しています。技術職員・支援員はこれらの機器を研究者に有効に利用していただくために技術的なサポートを行っています。
トレーニングコース

実験生物学者向けのバイオインフォマティクスの講座として、ゲノムインフォマティクストレーニングコース(GITC)を年に 4 回ほど開催しています。技術職員・支援員は講師や事務局を務め、コースの運営に関わっています。
バイオイメージング解析室(高木・斎田)
光を駆使して生命の秘密を探る。
光学解析室では光をツールとする研究機器の管理と運用を行っています。
主な設置機器は大型スペクトログラフと顕微鏡です。技術職員はこれらの機器の維持管理および利用者の技術支援を行っています。
大型スペクトログラフ

世界最大の超大型分光照射設備です。生命は地球に誕生して以来、様々な方法で光と関わってきました。光をエネルギー源として利用したり、情報源としても使います。植物の光合成や動物の視覚、体内時計などがその代表です。大型スペクトログラフはこのような光と生物の関係を調べる研究に使用されています。
顕微鏡類

共焦点レーザー顕微鏡や二光子顕微鏡と言った大型の顕微鏡から、蛍光顕微鏡や蛍光実体顕微鏡などの小型の顕微鏡、画像解析ワークステーションまで、バイオイメージングに必要な機器を取り揃えています。
共同研究支援

機器の管理運用だけでなく、共同研究の支援も積極的に行っています。
外国人との英語の研究打ち合わせにも参加し、より高度な技術支援を目指しています。
データ統合解析室(西出・中村・杉浦)
ネットワークが無かった時代に戻れますか?
情報管理解析室では次世代シーケンサーや蛍光顕微鏡などから取得されたデータを解析するための生物情報解析システムを提供しています。また、研究所のネットワークの管理やセキュリティに対する啓もう活動を行っています。
技術職員・支援員はそれら計算機システム・所内ネットワークの維持管理、ユーザーへのサポート、Webサイト・Web予約システムの構築などを通して研究所の活動を支えています。
大容量高速データサーバー

次世代シークエンサーなどからはき出される大量のデータを収めるためのサーバー。日々増え続けるデータ量に対応することが大きな課題です。
アクセスポイント

所内に張り巡らされたネットワークは今ではなくてはならないインフラの一つです。無線LANによりどこでもワイヤレスでインターネットに接続可能な環境を構築しています。
アイソトープ実験センター(松田・澤田・飯沼)
アイソトープって?
「アイソトープ isotope」は、日本語では「同位元素」ですが、ここでは「ラジオアイソトープ RadioIsotope(放射性同位元素)、以下RI」の略称です。アイソトープ 実験センター は、放射線を発生する試薬(たとえば、放射性リンを含むDNAや、放射性炭素を含む糖など)を使用するための施設です。技術職員は施設が安全に使用されるために様々な業務を行います。
教育訓練

技術職員は、実験者がRIを安全に使用するための教育訓練を行います。RIを扱うためには、講習を年に1回受講することが法令で義務付けられています。
事故を未然に防ぐ

RIを安全に使用するために、実験室の設備等に異常がないかを定期的に点検します。写真は、天井の点検口から換気ダクト・配管などの設備に劣化や破損がないかを確認しているところです。
汚染検査

RIを使用する実験台・流しはもちろんのこと、床やドアノブなども汚染されていないか法令に基づいて月に1回チェックします。専用のろ紙で拭き取り、放射線測定機(液体シンチレーションカウンタ等)で測定します。
IBBPセンター(加藤)
~あなたの大切なサンプルを未来へ~ IBBPセンターでバックアップ保管
IBBPセンターは、研究途上の生物遺伝資源をバックアップ保管するための施設で、国内の多くの研究者に利用していただいています。バックアップ保管とそのデータベース運用管理業務の他、施設の運用保守や技術開発のための支援業務などに従事しています。
生物遺伝資源バックアップ保管

DNA/RNA、タンパク質(抗体)、培養細胞、微生物、植物(種子,組織)、動物(精子,胚)などを、液体窒素タンクと低温低湿室で保管しています。多種多様な生物遺伝資源の保管に対応するため、幅広い知識と柔軟性を求められます。 また、学会などでIBBPの広報活動も行っています。
新規保存技術開発

超低温での保存方法が開発されていない生物種は多く、新規保存技術開発のための共同利用研究のサポートの他、研究集会(Cryopreservation Conference)、技術講習会開催の運営業務など、新規保存技術開発を推進するための支援を行っています。
施設運用保守

保管施設の点検や定期的な保守、機器のメンテナンスを行います。液体窒素は高圧ガス保安法に基づく点検など、その他、温度や湿度の常時監視、輸送容器(ドライシッパー)のメンテナンス、生物遺伝資源バックアップ保管のためのデータベース(IBBP-easy)の運用など、多岐にわたる施設や機器の管理を行っています。
研究部門(水谷・田中・野田・西本・林・大井・森・岡・水口・内海・竹内・尾納)
研究室の活動を表からサポート。
ゼニゴケ

生育も早く、遺伝子改変も比較的容易で、植物研究において近年広く使われ始めています。(林)
テトラヒメナ

DNAとタンパク質の複合体であるクロマチンのダイナミックな構造変化が、生命現象に与える影響を分子レベルで解析しています。(西本)
電気泳動

遺伝子改変マウスを用いて、分子生物学をはじめとする種々の手法により、生殖幹細胞研究の支援を行っています。写真はアガロース電気泳動により遺伝子型判定を行う様子です。(水口)
小型魚類飼育室

分子発生学研究部門では、生き物の形作りの仕組みをゼブラフィッシュなどのモデル動物を用いて研究しています。写真はゼブラフィッシュの飼育設備で餌やりをしているところです。(内海)
マウス初期胚

組織学的手法を用いてマウス初期胚の観察を行っています。写真はHE染色した子宮内の受精後3日目のマウス胚です。(岡)
KIゼブラフィッシュ

(竹内)
RNAi(RNA干渉)

遺伝子の機能を調べるためには、目的の遺伝子の機能を低下、破壊したり、増幅させて、生き物に現れる変化を観察します。RNAi は、面倒な遺伝子組換えを行わず、標的の遺伝子の機能を低下させる(ノックダウン)手法の一つです。写真は、ヘラクレスオオカブトの幼虫に二本鎖RNAを投与し、蛹や成虫に変化が起こるか実験をしています。(水谷)
ミヤコグサ

ミヤコグサ Lotus japonicusは日本を含むアジアの温帯地域に広く自生しているマメ科の草本です。ライフサイクルが短く、実験室内での遺伝解析が容易などの利点により、マメ科のモデル植物として広く利用されています。(田中)
ヒメツリガネゴケ
ヒメツリガネゴケは形質転換も容易で、生物の進化を研究するためのモデル植物として利用されています。写真はプレートで培養中のヒメツリガネゴケ。(大井)
共通機器の管理
縁の下の力持ち。
研究所では研究者に対して様々なサービスを提供しています。例えば水道をひねると純水が出る、実験に必須な氷がいつでも手に入る、液体窒素もいつでも利用可能など。技術職員はこれらの業務のうちいくつかを担当しており、研究所の活動を影から支えています。
純水製造装置

実験には混ざりものがないきれいな水が必要です。家の水道のように、各実験室の専用の蛇口をひねるといつでもきれいな水が出ます。
製氷機

分子生物学の実験では温度コントロールが需要です。エリアごとに製氷機が置かれており、冷却に必要な氷がいつでも手に入ります。
大型プリンター

学会前に大活躍する大型プリンター。ただ、ちょっと癖があります。困ったときには技術職員が手助け。なんとか間に合う?
職場の労働安全衛生に関すること
安全はそこにあるのではなく、作るもの。
研究所には安全委員会が置かれ、所内の安全について情報共有を行っています。また、各安全委員は所属する研究室・施設の安全を統括するとともに、所内の他部署へ安全衛生の巡視を行うことでお互いの安全意識の向上に努めています。
安全衛生管理室

職場環境を守るための安全衛生管理室が設置されており、技術課メンバーもスタッフとして加わっています。所内の安全確保のため、巡視活動や試薬管理などを通じて日々改善につと止めています。
巡視

技術課メンバーで衛生管理者の資格を持つ者が安全委員とともに定期的に各室を巡回し点検しています。時には厳しい指摘を行い、職場環境の改善に尽力しています。
試薬保管室

毒劇物などは厳重に保管されています。特に毒物はカード式の鍵がないと入室不可の部屋で保管しています。
廃棄物処理室

廃棄物処理室は、基生研と生理研の両研究所で発生した実験廃液や感染性廃棄物を適正に回収し、廃棄物処理業者へ委託します。
技術課セミナー
自分のため、みんなのため。
通常は月曜日のミーティング後に技術課メンバーが最新の技術や関連した話題についてのセミナーを行っています。他の人が何をしているか、何に詳しいかを知ることで、困ったときに相談する相手がわかります。同時にプレゼン技術の向上にも一役買っています。
また、個々人がその年の業務内容をまとめ整理し報告する機会として、技術報告セミナーを秋に行っています。
セミナーの様子

色々な話題が取り上げられています。最新技術から普段の仕事での困りごとまで。
技術報告セミナー

一年の仕事の集大成です。自分の仕事を振り返るいい機会でもあります。
技術課研修
新たなことへの挑戦。
技術課では個人の能力を高めるための研修を行っています。技術課の中で専門的な知識を持つものが講師となり、講義や実技実習を行うことでお互いの能力向上に努めています。場合によっては外部から講師を招くこともあります。
電気の取り扱い実習

ほとんどの実験装置は電気を動力しており、コンセントにプラグを差し込むだけで機器は動きます。ただし、電気器具は取り扱いを間違えると事故につながります。本研修では電気の基礎知識から簡単な電気工作まで幅広い内容を取り扱いました。講師は技術職員で第2種電気工事士の資格保持者が務めました。(講師:諸岡)
デジタルカメラの基礎と撮影

一眼レフカメラの基本~被写界深度とレンズによる遠近感の違いを体感してみる~と題して、カメラの基礎的な知識についての講義と撮影実習を行いました。(講師:竹内)
生物学研究現場のための写真撮影術

広報室の方を講師に招いて写真撮影技術について勉強しました。広報室は、研究材料である生き物から研究現場や研究会の集合写真など、様々な写真を撮影しています。講義では、デジタル一眼レフカメラでの撮影のテクニックやコツなど、多くの経験を通して得た知識を熱く語って頂きました。(講師:広報室・倉田さん)
情報セキュリティ

昨今、インターネットの普及によりコンピューターウイルス対策などの情報セキュリティの重要性が説かれています。技術課においてもセキュリティに対する意識を高めるため、情報管理解析室の職員が講師となり機構における対策について講義を行いました。(講師:中村)
CRISに触れてみよう。

CRIS とは、薬品管理システム(Chemical Registration Information System, )のことで、2018年度から基生研でも導入することになりました。導入に先立ち、システムの概要と使い方を学びました。(講師:諸岡)
テレビ会議システムを使ってみよう。

所内に設置されているテレビ会議システムの活用を目指して、実際の使用方法を体験しました。(講師:中村)
耐震固定研修

機器の壁や床への耐震固定作業は、業者に依頼することもできますが、実験室の小規模のレイアウト変更等で、都度業者に依頼するのは費用もかかり先送りになりがちです。そこで、小規模な固定は自分たちで行えるよう、耐震固定の方法や工具について座学と実習を交えて学び、最後には実際の機器の固定作業も行いました。(講師:諸岡)
ミーティング
情報共有も大切です・・・研究所のこと、技術課のこと。
毎週月曜の朝に技術課メンバーが集まり、ミーティングを行っています。課長らからの所内の会議報告や技術課運営に関する報告、各委員会からの報告などが行われ、情報を共有しています。
ミーティング

教授会議の内容などが報告されます。研究所の動向を知るまたとないチャンスです。
生物学技術研究会
全国の技術職員が気軽に集い、議論できる場所。
全国の生物系の技術職員が集まり、発表できる場として生物学技術研究会を主催しています。
以下に2016年度に行われた研究会について紹介します。
口演発表

口演発表では各種技術に関する講演があり、質疑応答でも活発な議論が交わされていました。
ポスター発表

ポスターの前で活発な議論が交わされました。新たな試みとして、発表の前にスライドを使って1分間で内容についてプレゼンする時間を設けております。
実物の展示

特別企画として、分子研の方より発表のあった加工技術に関するサンプルの展示がありました。
職場体験
研究者は将来のなりたい職業にランクイン!?
研究所では地域貢献の一環として、主に岡崎市内の中学生を対象に職場体験を受け入れています。技術課でも受け入れを行っており、DNAの抽出といった分子生物学の実験手法や施設の管理業務などを体験していただいています。
また、全国の中学校・高校から見学対応も行っております。
フローサイトメーターでの測定

最新の装置を使い細胞の核に含まれるDNAの量を測定しました。キャベツを刻むというお料理教室のような作業ですが、これでも最先端の手法の一つです。楽しみながら研究の一端に触れていただきました。
実は講師役の技術職員も実験がうまくいくかドキドキしていました。